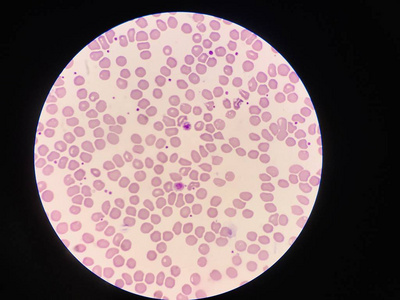
红细胞背景上有两个巨大的血小板.照片

大血小板

巨大血小板
图片尺寸441x280
后来,在女性患者外周血涂片中发现有巨大血小板和中性粒细胞包涵体
图片尺寸472x345
大血小板血涂片
图片尺寸320x240
血红细胞上的巨大血小板.
图片尺寸1200x948
巨/大血小板导致的血小板计数假性减少如何处理?
图片尺寸325x357
血液肿瘤血小板聚集巨大血小板在血液涂片照片
图片尺寸296x300
意识到事情并不那么简单,立马拿到显微镜下仔细观察,镜下可见大血小板
图片尺寸1080x719
满片尽是巨大血小板怎么破
图片尺寸750x1000
记一例edta导致的血小板卫星现象
图片尺寸1000x1333
一例巨大血小板病例引发的深思
图片尺寸486x645
红细胞背景上有两个巨大的血小板.照片
图片尺寸400x300
健康养生:如何通过食物控制改善血液中的血小板形成?
图片尺寸640x645
分享一例大血小板增多引起的血小板假性减低病例
图片尺寸720x1717
血涂片瑞氏染色x1000 血小板聚集由于edta抗凝剂不影响血细胞的形态
图片尺寸1080x1193
涨姿势!放大4000倍的血细胞,终于看到自己的血小板是什么样子的了
图片尺寸1728x1080
血小板
图片尺寸1200x879
红色血液中的红色血小板
图片尺寸800x500
血液涂片上的巨大血小板
图片尺寸1200x803
褚长龙大夫带你了解血小板增多症病因如何治疗
图片尺寸445x589
图19 巨大血小板,胞体直径>5um,提示巨大血小板综合征(bss),可能或
图片尺寸1080x814